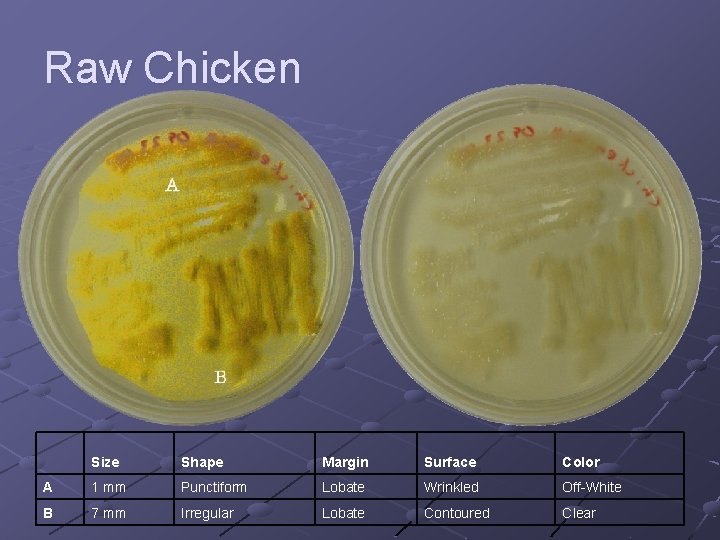
Raw Chicken Size Shape Margin Surface Color A 1 mm Punctiform Lobate Wrinkled Off-White
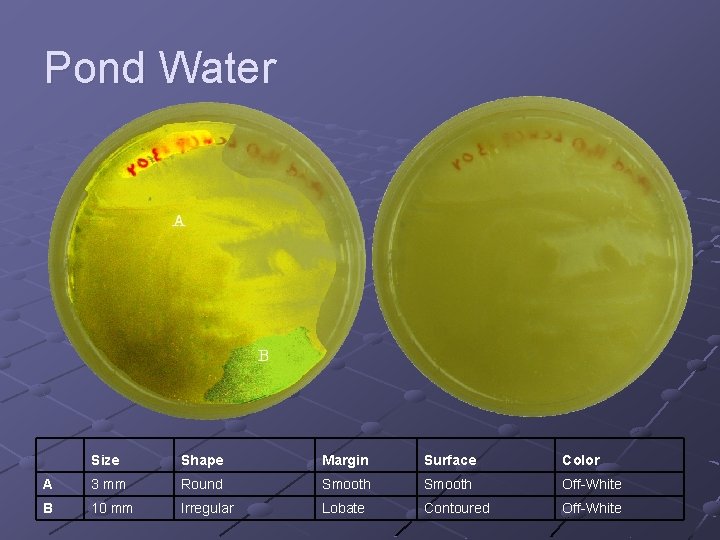
Pond Water Size Shape Margin Surface Color A 3 mm Round Smooth Off-White B

Bacterial Diversity The Examination of Bacterial Colonies in

Bacterial Diversity The Examination of Bacterial Colonies in Selected Environments By Lara Hartman and Daniel Arbeider

Purpose Explore the bacterial diversity found in: n n n Air Raw Chicken Soil Pond Water Washed & Unwashed Hands Library Table Establish which environment supports the greatest diversity of bacteria. Compare the data generated to determine if our hypothesis is supported.

Hypothesis Pond water will contain the greatest diversity of bacteria when compared to other observed environments.

Methods n n n Label each Petri dish according to the environment tested. To isolate bacterial colonies from the soil, pond water, chicken, and the PSU library table the “Streak Plate method” was used. For the air sample the lid will be removed for the duration of the experiment. For washed and unwashed hands, a thumb will be pressed on the surface of the agar. Incubate all plates for 1 week at 22 C.

Air Size Shape Margin Surface Color A 15 mm Irregular Lobate Smooth Milk-White B 5 mm Round Smooth Concentric Pale Yellow C 6 mm Round Curled Concentric White D 6 mm Round Smooth Off-White E 14 mm Irregular Lobate Contoured Mustard
Raw Chicken Size Shape Margin Surface Color A 1 mm Punctiform Lobate Wrinkled Off-White B 7 mm Irregular Lobate Contoured Clear

Soil Size Shape Margin Surface Color A 6 mm Irregular Lobate Smooth Off-White B 7 mm Irregular F u n g u s Filamentous Contoured White C 30 mm Irregular Lobate Contoured Clear
Pond Water Size Shape Margin Surface Color A 3 mm Round Smooth Off-White B 10 mm Irregular Lobate Contoured Off-White

Washed and Unwashed Hands Size Shape Margin Surface Color A 59 mm Irregular Wavy Smooth Off-White B 7 mm Irregular Filamentous Contoured White C 13 mm Irregular Lobate Smooth White

Library Table Size Shape Margin Surface Color A 15 mm Irregular Lobate Smooth White B 6 mm Round Wavy Concentric Yellow C 11 mm Round Smooth Concentric Yellow F u n g u s D E 3 mm Round Smooth Orange

Data Interpretation After one week, observations were made of the colony morphology of the different bacterial species in each environment. Charts were constructed to compare the diversity and abundance of bacteria in the various environments. Our data clearly showed that the hypothesis under investigation was not supported; however, it is reasoned that the pond water sample was not the best representation of aquatic life. In our next experiment all layers, top – middle-bottom, will be analyzed.

Escherichia coli Role: n Produces Vitamin K in the intestinal tract. Pathogenic effects: n n Human urinary tract infections Diarrhea Pneumonia (linked) Meningitis (linked)

E. coli How E. coli infects: n n n E. coli and how it infects – Part 1 E. coli and how it infects – Part 2 E. coli and how it infects – Part 3 Treatments: n Antibiotics are not recommended. (May cause shock) Studies: n n Antibiotic treatment increases risk of urinary tract infections from 8% (no treatment) to 56% (antibiotic treatment). E. coli develops antibiotic resistance quickly.

E. coli Control Antibiotic Dose Zone of Inhibition Sensitivity 1 Steptomycin 10 mg 5 mm Sensitive 2 Penicillin 10 mg 0 mm Not Sensitive 3 Erythromycin 15 mg 3 mm Sensitive 4 Tetracyclin 30 mg 7 mm Sensitive 5 Kanamycin 30 mg 5 mm Sensitive 6 Chloramphenicol 30 mg 12 mm Very Sensitive 7 Nalidixic Acid 30 mg 11 mm Very Sensitive 8 Novobiacin 30 mg 0 mm Not Sensitive

Sources • Carter Brown, M. E. , and J. G. Morgan. Investigating Biology: A Laboratory Manual for Biology. San Francisco: Benjamin Cummings, 2002 • Dennis Liu, Ph. D. , and B. Brett Finlay, Ph. D. Enteropathogenic E. coli Infection Mechanism. Retrieved November 2 2004, from http: //www. savetheantibiotic. com/public_html/0_Educators/bacteria_mov 1. html • . Craig S. Wong, Srdjan Jelacic, Rebecca L. Habeeb, Sandra L. Watkins, Phillip I. Tarr; Early Release article, The New England Journal of Medicine; May 23, 2000. Retreived November 2, 2004, from http: //www. coloradohealthsite. org/CHNReports/antibioticsandecoli. html
- Slides: 15